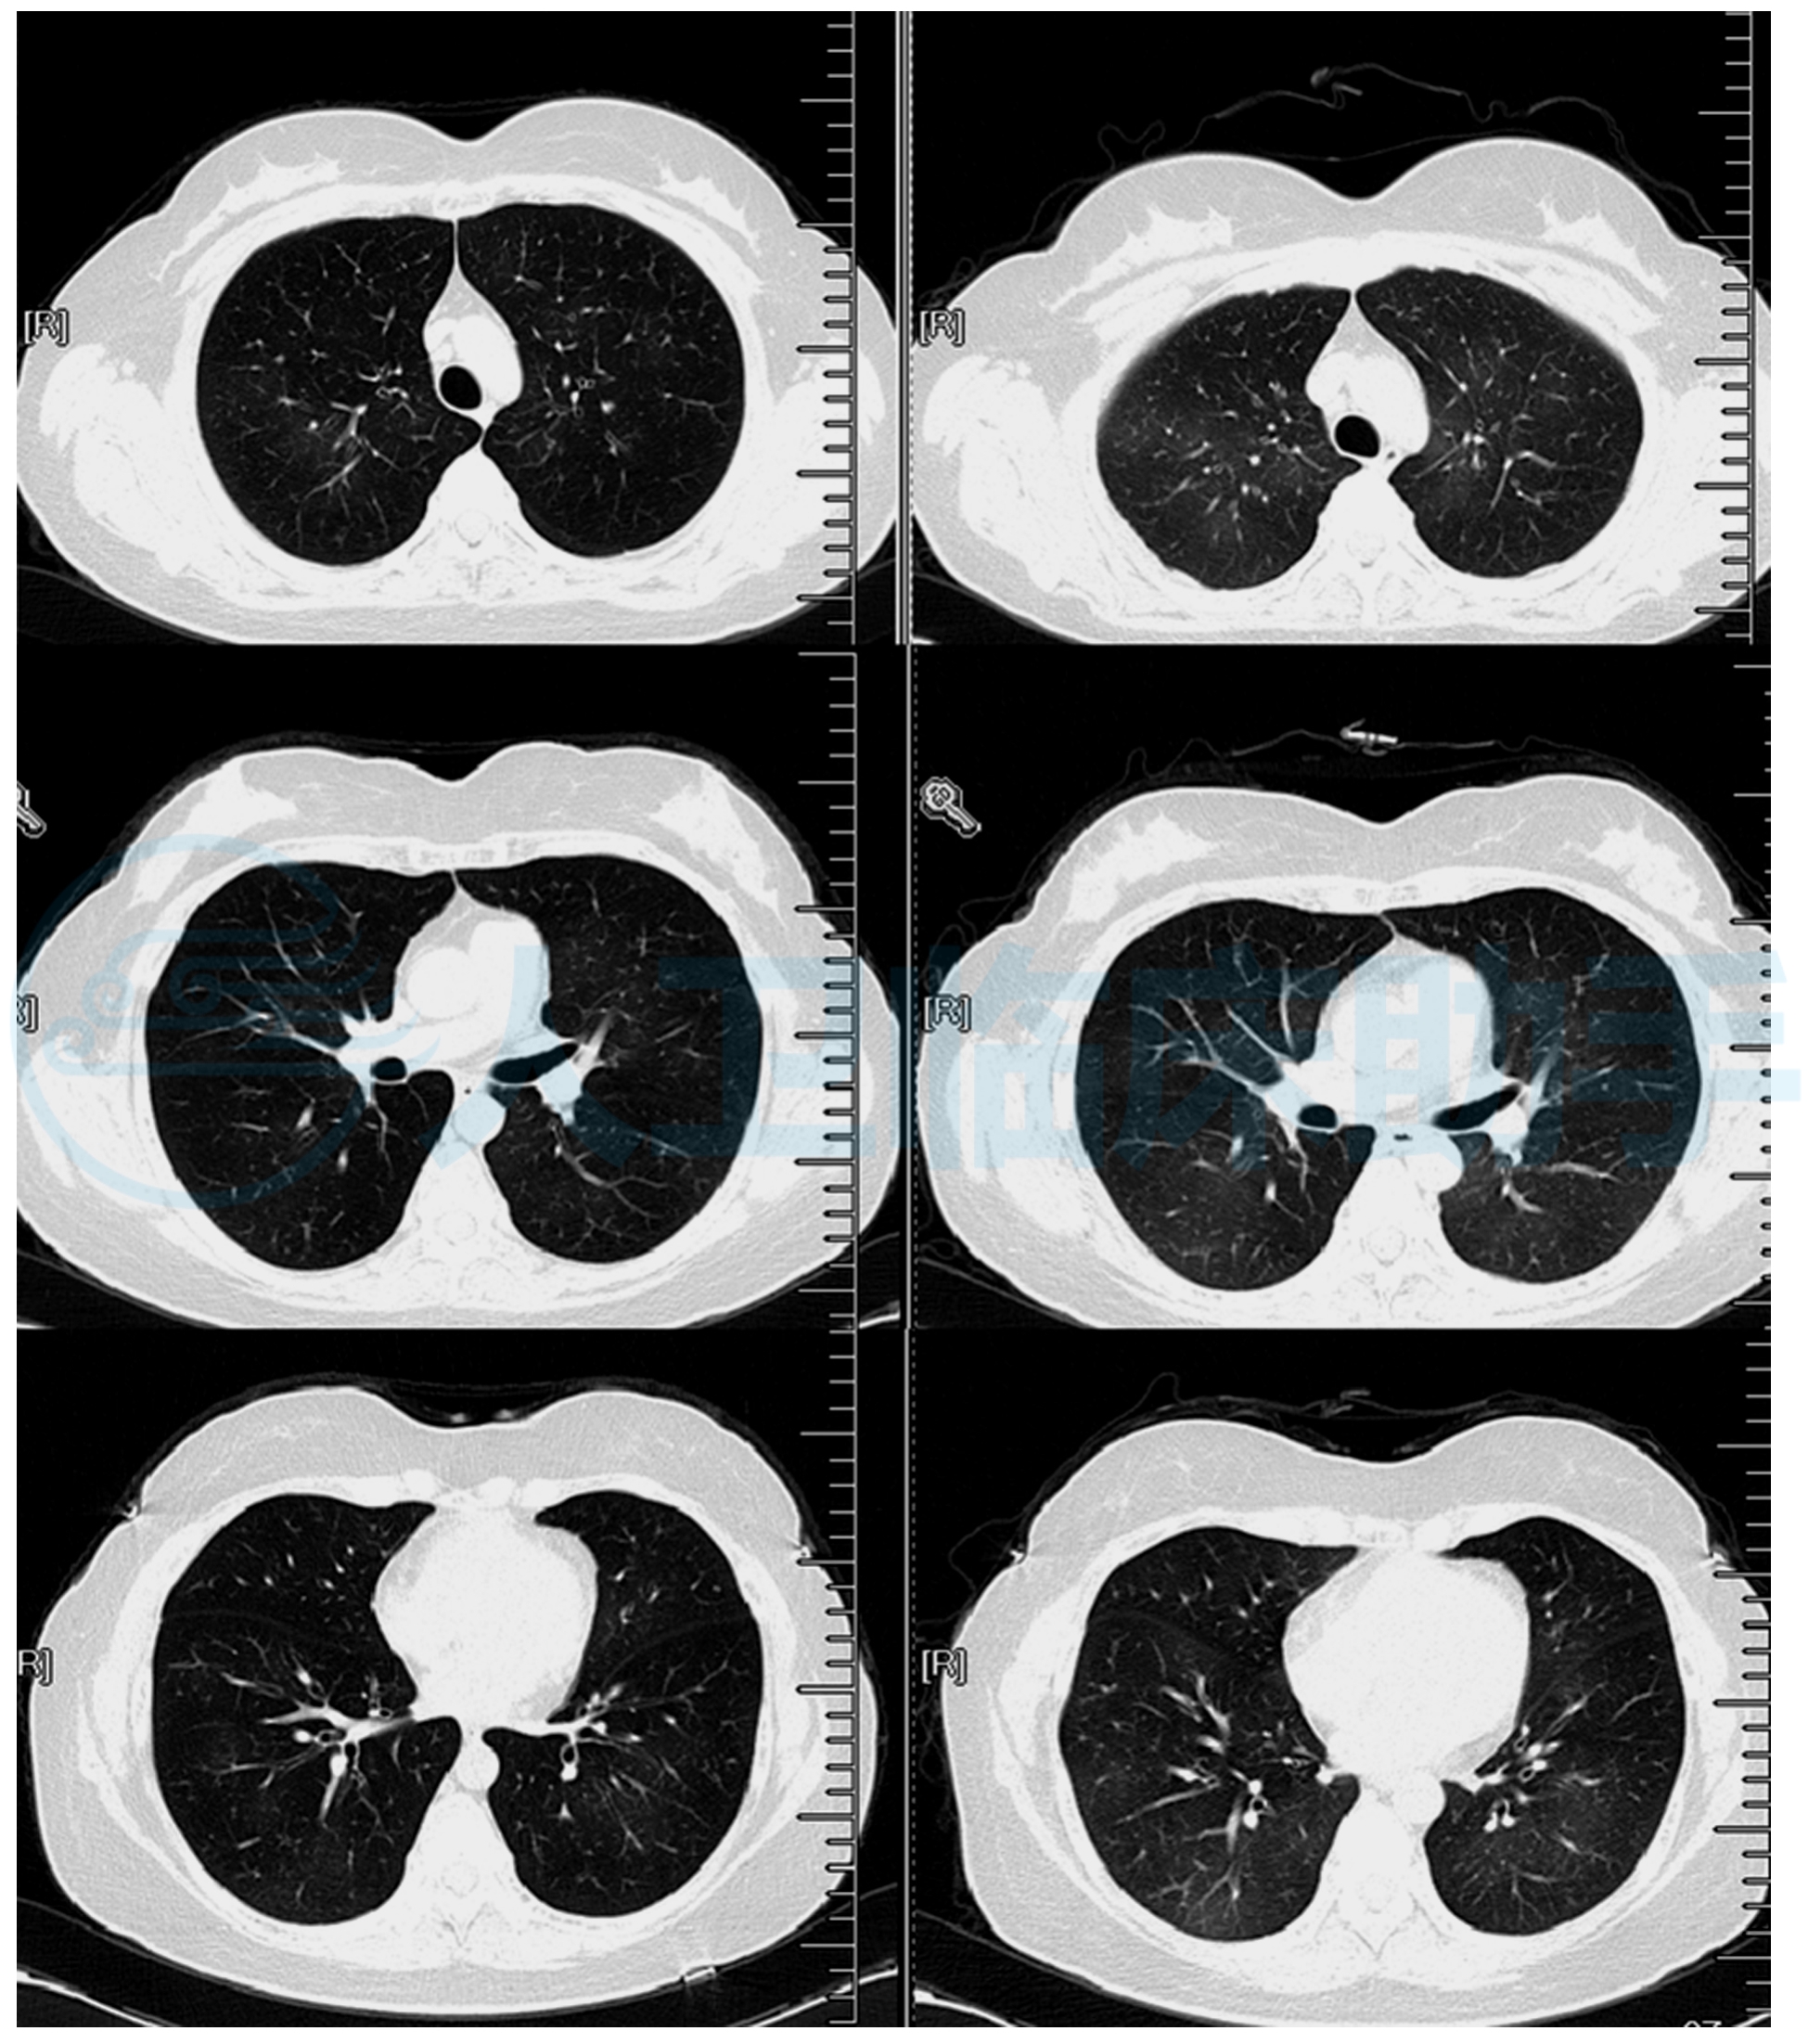
肺纹理增多:如同墙壁上的细小纹路,常见于长期吸烟者,工作环境差或

ct肺纹理增多

肺纹理增多:如同墙壁上的细小纹路,常见于长期吸烟者,工作环境差或
图片尺寸1949x2203
肺纹理增多多久能恢复?
图片尺寸720x960
看完你再也不敢忽视!
图片尺寸750x1000
医生科普揭秘双肺纹理增粗
图片尺寸1200x1600
肺纹理增多什么意思,哪些疾病信号?
图片尺寸1280x1280
双肺纹理增多 影像显示肺部血管和支气管纹理较正常更为密集,可能与
图片尺寸456x452
很多女性在进行胸部 x 光或 ct 检查后,会被告知存在肺纹理增多的
图片尺寸1242x1660
肺纹理增多严重吗?是什么病?怎么办?医生帮你解答清楚
图片尺寸1106x780
肺纹理增粗增多紊乱模糊
图片尺寸1080x1443
肺ct报告上提示 肺纹理增多,增多 代表着什么
图片尺寸640x875
1,纹理增粗 肺部纹理增粗往往提示支气管及其周围组织存在慢性炎症
图片尺寸695x566
这 5 个习惯保持住,再差的肺也能慢慢改善
图片尺寸2532x2072
肺部ct肺ctct胸膜增厚怎么看工业肺ctct显示肺部陈旧病变肺纹理 ct
图片尺寸1557x1280
感染新冠双肺纹理增多
图片尺寸1280x1706
入院后,查胸部增强ct提示典型的蝴蝶症
图片尺寸1226x908
前一天胸片只提示双肺纹理增多,今天住院查肺ct提示重症肺炎,左肺肺实
图片尺寸690x919
"肺纹理增多",是一种什么病?会不会很严重?医生详解
图片尺寸601x401
再讲讲胸片里面的肺纹理增粗和斑片影
图片尺寸1008x920
肺ct的暗语大全,一次性全都给你说明白!文章很长希望你坚持看完!
图片尺寸2048x1966
肺ct报告有这 4 个描述,可放宽心!基本没什么风险
图片尺寸2292x2000